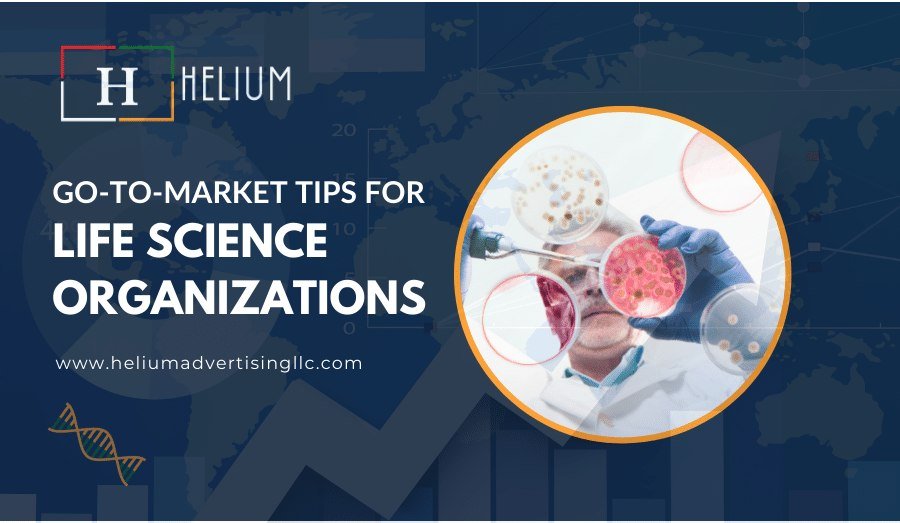
Go-to-Market Tips for Life Science Organizations

This site uses cookies. By continuing to browse the site you are agreeing to our use of cookies Find out more here
manoj heliumadvertisingllc
2 years ago
Market Research Companies in Saudi Arabia...
Helium is the leading full-service market research agency in Saudi Arabia and the Middle East.
How To Build a Sustainable Exhibition Stands?
Are you looking to make your next show stand more sustainable?A sustainable exhibition stand contractor will minimise your carbon...
Go-to-Market Tips for Life Science Organizations
Listed here are five ideas for staying on top of the competition in life science marketing.Helium Advertising is a known name in life...
Life Science Marketing Trends in 2024
In this article, we'll explore the top marketing trends for 2024, from personalization to AI. Need help to stay up to date with life...
Trade Show Planning Pre-Show Checklist
Trade Show Planning Pre-Show Checklist
Maximizing Your Experience at Healthcare...
Maximizing Your Experience at Healthcare Exhibitions in UAE
How to Acquire ROI on Exhibitions
Exhibitions are one of the perfect ways for organizations of different sizes to showcase novel services or products to potential customers...
How to Effectively Plan for Life Science...
How to Effectively Plan for Life Science Conferences and exhibitions